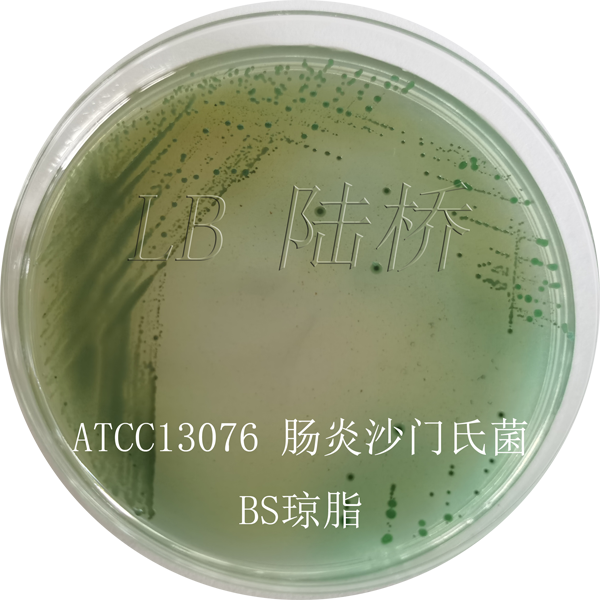
天然培养基为什么不需要另加微量元素（微量元素培养基配制）-硒宝网

天然培养基为什么不需要另加微量元素(微量元素培养基配制)
大连医科大学 生物技术专业 培养基 3.1 培养基的基本要求 单位培养基能够产生最大量的目的产物; 能够使目的产物的合成速率最大; 能够使副产物合成的量最少; 质量稳定、价格低廉、易长期获得; 不影响通气搅拌性能和后处理。 3.2 培养基的成分及来源 培养基的基本要素 碳源、氮源、无机盐和微量元素、水、生长调节物质。 3.3 发酵培养基的类型 按营养物质的来源 按培养基形态 按生产用途 发酵培养基的类型 ※正交试验设计(Orthogonal experimental design) 均匀分散,齐整可比 是一种高效率、快速、经济的实验设计方法 日本著名的统计学家田口玄一将正交试验选择的水平组合列成表格,称为正交表 2、正交实验的表头设计 表头设计是正交设计的关键,它承担着将各因素及交互作用合理安排到正交表的各列中的重要任务,因此一个表头设计就是一个设计方案。 表头设计的主要步骤 (1)确定列数?? (2)确定各因素的水平数 (3)选定正交表 (4)表头安排?? 作 业 1、某培养基影响因素与水平如下,试问应采用哪种正交表进行实验? 1、 正交表的记号及含义 正交表的列数 (最多能安排的因素个数, 包括交互作用、误差等) 正交表的行数 (需要做的试验次数) 各因素的水平数 (各因素的水平数相等) q 正交表的代号 如 表示 表示各因素的水平数为2, 做8次试验,最多考虑7个 因素(含交互作用)的正 交表。
根据正交表的数据结构看出,正交表是一个n行c列的表,其中第j列由数码1,2,… Sj 组成,这些数码均各出现N/S 次,例如表11中,第二列的数码个数为3,S=3 ,即由1、2、3组成,各数码均出现3次。 正交表的特点 1、正交表中任意一列中,不同的数字出现的次数相等; 表示:在试验安排中,所挑选出来的水平组合是均匀分布的(每个因素的各水平出现的次数相同)——均衡分散性 2、正交表中任意两列,把同行的两个数字看成有序数 对时,所有可能的数对出现的次数相同。 表示:任意两因素的各种水平的搭配在所选试验中出现的次数相等——整齐可比性 以上是设计正交试验表的基本准则(5)组织实施方案?? 整个设计过程一句话归纳为: “因素顺序上列 水平对号入座 实验横着作”。 ※方法1 直观分析(极差分析) (1)计算极差,确定因素的主次顺序第j列的极差极差越大,说明这个因素的水平改变对试验结果的 影响越大,极差最大的那个因素,就是最主要的因素。 3、结果统计方法 甘露聚糖 乙硫氨酸 溴化物、硫脲 硫磺化合物、乙硫氨酸 L-蛋氨酸 巴比妥药物 甘露糖链霉素 链霉素 金霉素 金霉素 头孢霉素N 其他利福霉素 链霉素 去甲链霉素 四环素 去甲金霉素 头孢霉素C 利福霉素B 抑制剂 被抑制的产物 产物 某些代谢产物的抑制剂 产孢子用 孢子 按生产用途 供孢子发芽和菌体生长繁殖,营养丰富、完整,浓度不高 种子 供菌体生长繁殖和最大限度地获得目的产物用的 发酵 液+琼脂,微好氧细菌的培养或运动能力确定 半固体 用于菌种分离、保藏、观察、计数、鉴定等 固体 培养种子和发酵时用 液体 按培养基形态 定量工作研究用,生长慢,营养成分简单 合成 异养微生物生长,一般自养型微生物不能生长 天然 按营养物质的来源 特点 类型 依据 1、按培养基物质来源 1)合成培养基 ? 所用原料的化学成分明确、稳定如葡萄糖、硫酸铵 ? 适于研究菌种基本代谢和过程的物质变化等科研工作;在生产某些疫苗的过程中,为了防止异性蛋白质等杂质掺入,也常用合成培养基; ? 营养单一、价格较高,不适于大规模生产 2)天然培养基 ? 原料是一些天然动、植物产品如花生饼粉、蛋白胨等 ? 来源广泛(大多为农副产品)、营养丰富、价格低廉、适于工业化生产 ? 一般不需要另加微量元素、维生素等物质 ? 由于成分复杂,不易重复,如对原料质量等方面不加控制会影响生产稳定性 2、按培养基形态分 1)固体 ? 适于菌种和孢子的培养与保存,也广泛应用于有子实体的真菌类,如香菇、白木耳等的生产; ? 近年来由于机械化程度的提高,在发酵工业上又开始应用固体培养基进行大规模生产,其组分常用麸皮、大米、小米、木屑、禾壳等。
2)半固体 ? 琼脂0.5%-0.8% ? 主用于鉴定细菌、观察细菌运动特征及噬菌体的效价测定等 3)液体 发酵工业大规模使用的培养基 3. 按用途分 孢子培养基 种子培养基 发酵培养基 供菌种繁殖孢子的培养基,常用固体培养基。 1)孢子培养基 孢子培养基基本要求: 配制时需注意: A)营养不要太丰富(特别是有机氮源),否则不易产孢子。 如灰色链霉菌在葡萄糖-硝酸盐-其他盐的培养基上都能很好地生长和产生孢子,但若加入0.5%酵母膏或酪蛋白后,就只长菌体而不产孢子 B)所用无机盐的浓度要适量,否则会影响孢子量和孢子颜色。 C)注意pH和培养基的湿度。 基本要求是能使菌体迅速生长,产生较多优质孢子,且不易引起菌种发生变异。 常用孢子培养基: ◆ 麸皮培养基◆ 小米培养基 ◆ 大米培养基◆ 玉米碎屑培养基 ◆ 用葡萄糖、蛋白胨、牛肉膏和食盐等配制的琼脂斜面培养基 大米和小米常用作霉菌孢子培养基,因为它们含氮量少、疏松、表面积大,是良好的孢子培养基。 2)种子培养基 供孢子发芽、生长和菌体繁殖的培养基。 ? 营养要求比较丰富和完全,氮源和维生素的含量也要高些,但总浓度以略稀薄为好,这样可达较高的溶解氧,供大量菌体生长和繁殖。
? 种子培养基的成分要考虑在代谢过程中能维持稳定的pH,其成分还要根据不同菌种的主要特征而定。 ? 一般种子培养基都用营养丰富而完全的天然有机氮源,因为有些氨基酸能刺激孢子发芽。但无机氮源容易利用,有利菌体的迅速生长,所以在种子培养基中常包括有机氮源和无机氮源。 ? 最后一级的种子培养基的成分最好能较接近于发酵培养基,这样可使种子进入发酵培养基后能迅速适应,快速生长。 3)发酵培养基 ? 既要使种子接入后能迅速生长,达到一定的菌体浓度,又要使长好的菌体能迅速合成所需产物。因此,发酵培养基的组成除有菌体生长所必需的元素和化合物外,还要有合成产物所需的特定元素、前体和促进剂等。 供菌体生长、繁殖和合成大量代谢产物用的培养基。 ? 但若因生长和合成产物所需的总的碳源、氮源和其他营养物质总的浓度太高,或生长和合成产物两个阶段各需的最佳条件有求不同时,则可考虑培养基用分批补料工艺来加以满足。 生理代谢 菌种筛选 种子培养 发酵培养不同的发酵产物,不同的菌种所选择的发酵培养基是不同的。白酒 (chinese spirit)发酵:固体发酵培养基;果酒(fruit spirit)发酵:果汁 ;啤酒(beer) 发酵:麦芽汁液体培养基;酒精(alcohol)发酵:淀粉糖化醪 ;氨基酸(amino acid)发酵:水解糖液加其他营养成分;柠檬酸(citric acid)发酵:淀粉液化醪 ;乳酸(lactic acid)发酵:淀粉糖化醪;甲烷(methane)发酵:复杂的有机废物发酵;抗生素(antibiotic)发酵:淀粉糖化醪 +豆饼粉+麸皮粉 一、培养基成分选择的原则 ? 一般只有小分子能够通过细胞膜进入细胞内进行代谢; ? 微生物能够利用复杂的大分子是由于分泌各种水解酶,在体外将大分子水解为微生物能直接利用的小分子; ? 微生物来源和种类不同,所分泌的水解酶系不同; ? 有的微生物由于水解酶系的缺乏,只能利用简单物质; 在考虑某一菌种对培养基的总体要求时,在成分选择时应注意以下几方面的问题: 1、菌体的同化能力 3.4 发酵培养基的设计和优化在碳源和氮源的选取时特别要注意,许多碳源和氮源都是复杂的有机大分子,如淀粉、黄豆饼粉等;用这类原料,微生物须具备分泌胞外淀粉酶和蛋白酶。

? 培养不能分泌淀粉酶的菌株,可先将淀粉糖化 ? 有些微生物,如大多数氨基酸产生菌,缺乏蛋白水解酶,可先将有机氮源水解 培养基成分选择的原则(continued) 以酿酒酵母为例:一般不含淀粉酶,不能利用可溶性淀粉;细胞内缺乏将硝酸根离子还原为铵离子的所需催化酶,所以做培养基优化时,我们用氮源时考虑各种氨盐等而少考虑各种硝酸盐类。 酶制剂的生产,也应考虑碳源的分解代谢阻遏的影响,对于许多诱导酶来说,易被利用的碳源(如葡萄糖或果糖)不利于产酶。 培养基成分选择的原则(continued) 2、代谢的阻遏和诱导 根据微生物的特性和培养目的,注意快速利用的碳(氮)源和慢速利用的碳(氮)源的配合,发挥各自优势,避其所短。 菌体利用葡萄糖时产生的分解代谢物可能阻遏或抑制某些产物合成所需的酶系的形成或酶的活性(葡萄糖效应);在抗生素发酵时,种子培养基所含的快速利用碳源和氮源往往比发酵培养基多;有时需考虑分批补料或连续补料。 有些产物会受氮源的诱导与阻遏,如通常蛋白酶的生产受培养基中蛋白质或多肽的诱导,而受铵盐、硝酸盐、氨基酸的阻遏,应考虑氮源以有机氮源(如蛋白质)为主。 不同生长阶段,对碳氮比的最适要求可能不同。
一般来讲,因为碳源既作为碳架参与菌体和产物的合成,又作为生命过程中的能源,故比例要求比氮源高。 培养基成分选择的原则(continued) 3、合适的碳氮比 ? 碳氮比对生长繁殖以及产物合成的影响极其显著 ? 氮源过多,会使菌体生长过旺,pH偏高,不利代谢产物的积累;氮源不足,则菌体繁殖量少,从而影响产量; ? 碳源过多则易形成较低的pH;碳源不足则容易引起菌体的衰老和自溶。 ? pH是微生物生长和代谢的极为重要的环境因子; ? 微生物在利用营养物质后,由于酸碱物质的积累或代谢酸碱物质的形成,会造成培养体系中pH的波动; ? 发酵过程中调节pH的方式一般不主张直接用酸碱来调节; ? 要保证发酵过程中pH能满足工艺的要求,合理配制培养基是决定因素,因而在配制培养基选取营养成分时,除了考虑营养需求外,也要考虑其代谢后对培养体系pH缓冲能力的影响。 培养基成分选择的原则(continued) 4、pH的要求 二、培养基的优化选择培养基成分,设计培养基配方,虽然有一些理论依据,但最终的确定是通过实验的方法获得的。 培养基设计与优化的大致步骤: 1)根据前人的经验和培养基配制的基本理论,初步确定可能的成分; 2)通过单因子实验确定最为适宜的培养基成分; 3)通过多因子实验确定各成分的最适浓度 单因子实验比较简单。
对于多因子实验,为了通过较少的实验次数获得所需的结果,常采用一些合理的实验设计方法,常用的有正交实验设计、响应面分析等。 类胡萝卜素高产菌Y11的培养基的优化 郭秒,食品与工业发酵,2004 (中文核心期刊) 原培养基: 初步确定可能的培养基成分(以碳源为例) 通过单因子实验确定适宜的培养基成分(以碳源为例) 考虑到成本:乙酸钠是较为合适的碳源 进一步实验:乙酸钠的浓度0.2%比较好 结果: 碳源:乙酸钠 0.2% 氮源:氯化铵 0.2%酵母膏 0.03% 无机盐:复合无机盐 0.05% 正交设计确定优化的配方 正交试验设计 1、 正交表的记号及含义 正交表的列数 (最多能安排的因素个数, 包括交互作用、误差等) 正交表的行数 (需要做的试验次数) 各因素的水平数 (各因素的水平数相等) q 正交表的代号 (改进后培养基) (原培养基) 改进后培养基的发酵结果 * 发酵工业培养基的设计 培养基:是指一切可供微生物细胞生长繁殖和合成各种代谢产物的营养物质。 碳源、氮源、无机盐、微量元素、水、生长辅助因子 培养基的作用: 满足菌体的生长 促进产物的形成 培养基 3.1 培养基配制基本要求 3.2 培养基的成分及来源 3.3 培养基的类型及功能 3.4 发酵培养基的设计和优化 一、碳源 主要功能: 1)为菌体的生长繁殖提供能源和合成菌体所必需的成分; 2)为合成目的产物提供所需的碳素成分 常用的碳源: 特殊情况下(如碳源贫乏时),蛋白质水解物或氨基酸等也可被微生物作为碳源使用。
糖类 油脂 有机酸 低碳醇等 1、糖类 ? 发酵培养基中使用最广泛的碳源; ? 主要有葡萄糖、糖蜜和淀粉糊精等 纯葡萄糖、水解淀粉 纯乳糖、乳清粉 大麦、花生粉、燕麦粉、黑麦粉等 甜菜糖蜜、甘蔗糖蜜、粗红糖、精白糖等 葡萄糖 乳糖 淀粉 蔗糖 来 源 糖类 工业上常用的糖类及来源 葡萄糖 ? 最易利用,几乎所有微生物都能利用 ? 葡萄糖常作为培养基的一种主要成分,并且作为加速微生物生长的一种有效糖。 ? 但过多的葡萄糖会过分加速菌体的呼吸,以至培养基中的溶解氧不能满足需要,使一些中间代谢物(如丙酮酸、乳酸、乙酸等)不能完全氧化而积累在菌体或培养基中,导致pH下降,影响某些酶的活性,从而抑制微生物的生长和产物的合成。 糖蜜 ? 制糖的结晶母液,它是制糖工业的副产物; ? 含有丰富的糖、氮类化合物、无机盐和维生素等,是微生物发酵培养基价廉物美的碳源; ? 糖蜜主要含有蔗糖,总糖可达50%-75%。 ? 糖蜜分甘蔗糖蜜和甜菜糖蜜,二者在糖的含量和无机盐的含量上有所不同,即使同一种糖蜜由于加工方法不同其成分也存在差异,因此使用时要注意。 淀粉糊精 ? 多糖,也是常用的碳源; ? 需经胞外酶水解成单糖后再被吸收利用; ? 使用淀粉可克服葡萄糖代谢过快的弊病,价格也比较低廉,在发酵工业中被普遍使用。
? 常用的淀粉为玉米、甘薯、马铃薯、木薯淀粉。 ? 油和脂肪也能被许多微生物作为碳源和能源 ? 这些微生物都具有比较活跃的脂肪酶,在脂肪酶的作用下,油或脂肪被水解为甘油和脂肪酸,在溶解氧的参与下,进一步氧化成CO2和H2O,并释放出大量的能量。 ? 当微生物利用脂肪作为碳源时,要供给比糖代谢更多的氧,不然大量的脂肪酸和代谢中的有机酸会积累,从而引起pH的下降,并影响微生物酶系统的作用。 ? 常用豆油、菜油、葵花籽油、猪油、鱼油、棉籽油等 2、油和脂肪 油、脂肪 甘油+脂肪酸 CO2+H2O ATP 脂肪酶 氧气 ? 一些微生物对多种有机酸(如乳酸、柠檬酸、乙酸等)有很强的氧化能力,可以有机酸或有机酸盐作为碳源。 ? 有机酸的利用?;崾筽H上升,尤其是有机酸盐氧化时,常伴随着碱性物质的产生,使pH进一步上升。 如以醋酸盐为碳源时,反应如下: CH3COONa + 2O2 ? 2CO2 + H2O + NaOH 3、有机酸 ? 随着石油工业的发展,微生物工业的碳源也有所扩大。 ? 正烷烃(一般指从石油裂解中得到的14-18碳的直链烷烃混合物)已用于有机酸、氨基酸、维生素、抗生素和酶制剂的工业发酵中。
? 石油工业的发展促使乙醇产量的增加,乙醇代粮发酵的工艺发展也十分迅速,自然界中能同化乙醇的微生物和能同化糖质的微生物一样普遍,种类也相当多,乙醇作碳源其菌体得率比葡萄糖作碳源还高,因而乙醇已成功地应用于发酵工业的许多领域中,如利用乙醇生产单细胞蛋白 4、烃和醇类 二、氮源 有机氮源 豆饼(粕)粉、花生饼粉、鱼粉、蚕蛹粉、酵母粉、玉米浆、尿素等 无机氮源 铵盐、硝酸盐等 (由于细胞内的含氮物质都以氨基或亚氨基的形式存在,故铵态氮可以直接用于合成细胞物质;而硝态氮需还原成氨后才能被利用) 无机氮源和尿素、玉米浆等可被迅速利用,为速效氮; 蛋白质氮则需先水解成肽和氨基酸后才能被吸收利用, 属迟效氮 ? 氮源物质常对培养液pH产生影响 (NH4)SO4 ? 2NH3 + H2SO4 NaNO3 + 4H2 ? NH3 + 2H2O + NaOH 反应中所产生的NH3被菌体作为氮源利用后,培养液中就留下了酸性或碱性物质。 ? 在常用的无机氮中,硫酸铵被菌体利用后会使培养液的pH下降,为生理酸性物质; 硝酸钠被同化时则引起培养液pH上升,为生理碱性物质 作用:各种不一样 来源:C、N源,以盐的形式补充 用量:根据具体的产品,以实验决定 使用注意点 A. 对于其它渠道有可能带入的过多的某种无机离子和微量元素在发酵过程中必须加以考虑 三、无机盐和微量元素 B、使用时注意盐的形式(pH的变化) 例:黑曲酶NRRL-330,生产α-淀粉酶, pH对酶活的影响pH酶活 不加4.25120分钟 加 K2HPO45.4530分钟 加 KH2PO44.6275分钟 四、生长因子 概念: 微生物生长不可缺少的微量有机物质。

类别: 维生素、氨基酸、嘌呤嘧啶及其衍生物不是所有微生物都必需的,只是对于某些自己不能合成这些成分的微生物才是必不可少的营养物质。 ? 如以糖质原料为碳源的谷氨酸生产菌均为生物素缺陷型,以生物素为生长因子。 ? 又如目前所使用的赖氨酸产生菌几乎都是谷氨酸产生菌的各种突变株,均为生物素缺陷型,同时也是某些氨基酸如高丝氨酸的缺陷型,需要生物素和某些氨基酸作为生长因子。 提供生长因子的农副产品原料 1)玉米浆( corn steep liquor, CSL) ◇ 用亚硫酸浸泡玉米而得的浸泡液的浓缩液,也是玉米淀粉生产的副产品 ◇ 虽然主要用作氮源,但它含有丰富的氨基酸、核酸、维生素、无机盐等,常用作为提供生长因子的物质。 五、水 生理功能: 1)是微生物机体的重要组成部分 2)进行代谢反应的介质 3)营养物、代谢物、氧气等必须溶解于水后才能通过细胞表面进行正常的活动; 4)水的比热高,能有效吸收代谢过程中放出的热,使细胞内温度不致骤然上升;同时水又是热的良导体,有利于散热,可调节细胞温度。 ? 对于发酵工厂来说,恒定的水源是至关重要的,因为在不同水源中存在的各种因素对微生物发酵代谢影响甚大,特别是水中的矿物质组成对酿酒工业和淀粉糖化影响甚大。
? 水源质量的主要参数包括pH值、溶解氧、可溶性固体、污染程度以及矿物质组成和含量。 六、前体 (precursor) 概念: ——指某些化合物加入到发酵培养基中,能直接被微生物在生物合成过程中结合到产物分子中去,而其自身的结构并没有多大变化,但是产物的产量却因加入前体而又较大的提高。 发现: ? 最早是从青霉素的生产中被发现的。 ? 加入玉米浆后,青霉素单位可从20U/ml增加到100U/ml; ? 玉米浆中含有苯乙胺,它能被优先合成到青霉素分子中,从而提高青霉素G的产量。大多数前体,如苯乙酸对微生物的生长有毒性,以及菌体具有将前体氧化分解的能力,因此在生产中为了减少毒性和增加前体的利用率,常采用少量多次的工艺。 苯乙酸及其衍生物 苯氧乙酸 氯化物 氯化物 正丙醇 丙酸盐 ?-紫罗酮 ?-氨基丁酸 邻氨基苯甲酸 甘氨酸 青霉素G 青霉素V 金霉素 灰黄霉素 红霉素 核黄素 类胡萝卜素 L-异亮氨酸 L-色氨酸 L-丝氨酸 前体 产品 七、促进剂和抑制剂 1、促进剂:促进剂是指那些非细胞生长所必需的营养物,又非前体,但加入后却能提高产量的添加剂。 ? 促进剂不是前体或营养物 ? 可影响正常代谢,或促进中间代谢产物的积累,或提高次级代谢产物的产量 例如 ◇ 巴比妥可增加链霉素产生菌的抗自溶能力,推迟自溶时间,增加链霉素积累。 ◇ 谷氨酸棒杆菌生产赖氨酸时,加入红霉素可提高产量25%以上。 2、抑制剂抑制某些代谢途径的进行,同时刺激另一代谢途径,以致可以改变微生物的代谢途径。 如酵母厌氧发酵中加入亚硫酸盐或碱类,可以使酒精发酵受到抑制,而转入甘油发酵 * * *
